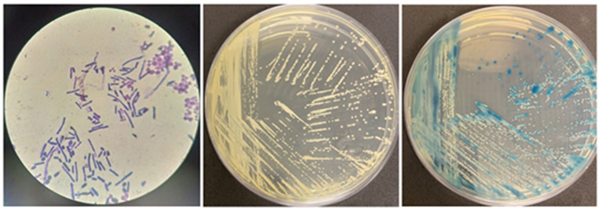
这种虫子 看到1只 你家里就有了1万只——不是蟑螂

这种虫子蛾蠓 看到1只 你家里就有了1万只—不是蟑螂
我打赌,你一定在浴室地漏或者厨房水槽旁,发现过下面这个长着毛茸茸翅膀的灰黑色小虫——
图片来源:Ausemade

这种虫子 看到1只 你家里就有了1万只——不是蟑螂
放大细节再看——
家里有它,你会嗞哇乱叫吗?图片来源:Wikimedia

这种虫子 看到1只 你家里就有了1万只——不是蟑螂
恭喜你!你发现了自然界中最成功适应城市下水道生活的昆虫。
这种看着像蛾子的小虫子叫做蛾蚋(ruì),也称蛾蠓。
居家最常见的一种叫做白斑蛾蚋(Clogmia albipunctata),因其翅膀上的白色斑点及全身似飞蛾一般的绒毛而得名。
白斑蛾蚋的体长不过几毫米,却以其令人惊叹的生存技能在城市的钢铁丛林中开辟出一个独特的生态位。
它们是下水道里的腐生清道夫,但同时也是蛰伏在卫生死角里的潜在传染源。

这种虫子 看到1只 你家里就有了1万只——不是蟑螂
看特写,白斑蛾蚋的名字很形象 图片来源:Wikimedia
下水道的昆虫之王
白斑蛾蚋所在的蛾蠓科是个大家族,拥有超过 2600 个成员。在蛾蠓科大家族中,当属白斑蛾蚋的分布范围最为广泛。
白斑蛾蚋喜好富含腐败有机质的阴暗生境,人类聚集区的下水道、洗脸台等会环境就是它的最爱,在世界各地的下水道里都有它的身影。
家里看到它,你的第一反应是?图片来源:zoomdrain.com

这种虫子 看到1只 你家里就有了1万只——不是蟑螂
白斑蛾蚋的成虫寿命一般只有短短十几天,它此时的飞行能力很弱,大部分时间只是待在墙壁上一动不动。
你在家里看到的成虫只是“九牛一毛”,真正的白斑蛾蚋大军正以幼虫形态隐藏在下水口的管道内,以有机腐烂物质为食。不
到一个月的时间,白斑蛾蚋就能在你家下水道完成一整个世代的生长发育。
下水道昆虫之王的一生 图片来源:参考资料[1]

这种虫子 看到1只 你家里就有了1万只——不是蟑螂
下水道混生活,不容易啊!
要在藏污纳垢的下水道中成长繁殖并壮大种群,并不是件易事。
为此,白斑蛾蚋发展出了一套独特的生存本领。
白斑蛾蚋的雌虫会将虫卵产在下水管道的管壁上,幼虫孵化后便会开启疯狂的进食模式。
它们用锯齿状的口器不断取食下水道中的各种物质,无论是人类的毛发碎屑,还是厨房垃圾的食物残渣,都是它们的美味食物。
白斑蛾蚋能将下水道中的各类物质照单全收,是因为其体内有着许多特殊菌群。
研究者将白斑蛾蚋幼虫肠道内的细菌进行分离培养后,得到了多种能产生淀粉酶和蛋白酶的细菌。
如此强大的肠道菌群,让白斑蛾蚋幼虫在污浊不堪的下水道中也活得非常滋润。
白斑蛾蚋幼虫肠道细菌产消化酶情况 图片来源:参考资料[7]

这种虫子 看到1只 你家里就有了1万只——不是蟑螂
在下水道生存的另一大难题,是时不时就会出现的“滔天洪水”。
好在蛾蠓身上有一套神奇的防水系统,秘密就藏在它那满身的绒毛里。
蛾蠓体表覆盖的数千根细毛并非装饰,在超高放大倍率的电子显微镜下,这些细毛呈现出精密的构造。
每根毛的表面有许多纳米级别的细小沟槽,共同形成了类似荷叶表面的超疏水层。
在水黾和溜蝇等其他逐水而居的昆虫中,也发现过非常相似的精密构造。
生活在相同环境的不同生物,选择用同一类构造来适应环境,这就是趋同演化的神奇之处。
蛾蠓身上的疏水结构放大图 图片来源:参考资料[4]

这种虫子 看到1只 你家里就有了1万只——不是蟑螂
当细小的水滴打在蛾蠓身上时,由于这些细毛的阻挡,它的身体不会直接被打湿。
这就像是给蛾蠓穿上了一件防水衣,让它们在潮湿的下水道中也能保持身体干燥,不会轻易被水流冲走。
如果水中带点低浓度的表面活性剂(肥皂水和洗洁精等),蛾蠓的翅膀依然能够保持不错的疏水性。
但浓度过高的清洁剂会大幅降低液体表面张力,此时蛾蠓体表的疏水性就会受到影响,液体便会渗过细毛层把它们的身体弄湿。
不过,即便全身湿透,蛾蠓体表的细毛也能形成一层薄薄的空气层,让其能够继续呼吸长达 5 小时之久。
科学家模拟各种大小的液滴和各种角度的水流对蛾蠓的影响 图片来源:参考资料 4

这种虫子 看到1只 你家里就有了1万只——不是蟑螂
这小虫子会咬我吗?
不像蚊子,白斑蛾蚋本身不咬人、不吸血,因此不会通过血液传播造成疾病。
在这一点上,它比蚊子、臭虫这类家中常客可友好太多了。
比起蛾蠓,家里更讨厌的虫子来了。图片来源:Wikimedia

这种虫子 看到1只 你家里就有了1万只——不是蟑螂
然而,白斑蛾蚋的体表构造也会变成病原体的温床。
它们常年生活在下水道中,身上难免携带大肠杆菌等细菌微生物。
但好在它们的运动能力有限,而且大部分时间都待在下水道里,因此它传染疾病的风险并不大。
由于白斑蛾蚋没有造成过群体感染事件,这种小虫子并未被疾控部门列为常规病媒生物监测对象,所以大家平常对它不必过度担心。

这种虫子 看到1只 你家里就有了1万只——不是蟑螂
根据国家标准 GB/T 31721-2015,蛾蠓并不属于病媒生物 图片来源:《病媒生物控制术语与分类》
需要警惕的是,白斑蛾蚋在医院特殊环境中可能会带来感染风险。
巴西某医院披露的案例显示,一重症监护病房爆发了酵母菌感染,追踪溯源后发现竟与排水系统中滋生的白斑蛾蚋种群相关。
感染的源头是被白斑蛾蚋排泄物污染的医疗设备,这些设备对 ICU 中的免疫缺陷患者构成了致命威胁。
另一家德国医院的案例显示,医院内捕获的白斑蛾蚋种群中,竟有 41.4%的个体携带多重耐药菌。
还有药敏试验发现,白斑蛾蚋肠道内发现一种名为松鼠葡萄球菌(Staphylococcus sciuri)的细菌,对万古霉素、四环素和环丙沙星等 6 种抗生素均呈现耐药性。
白斑蛾蚋身上的多重耐药菌可能导致难以治疗的医院感染事件,因此蛾蠓在医院环境中的潜在健康风险值得重视。
白斑蛾蚋体表病原体培养结果 图片来源:参考资料2
这种虫子 看到1只 你家里就有了1万只——不是蟑螂
各类资料在描述蛾蠓科昆虫的危害时,还会提到其寄生人体造成蝇蛆病的现象。
查询文献报道,临床上确实有一些由蛾蠓造成蝇蛆病的案例,但真实性有待考据。
有研究者统计分析了近百年中一共 51 篇蛾蠓蝇蛆病相关的文献案例,发现其中过半数(57.2%)的病例报道都是在泌尿生殖系统中发现的蛾蠓幼虫,而且都与较差的卫生环境和生活习惯相关。
另外,蛾蠓幼虫口器为咀嚼式口器,适合以刮取有机物碎片为食,并不适合采食人体组织。
和专门寄生人体的寄生性昆虫相比,蛾蠓幼虫身上也并无特殊的呼吸结构和附着结构。
因此,蛾蠓很可能并不能造成真正的蝇蛆病。(如果想了解人体蝇蛆病,还得看人肤蝇!)
某百科词条关于蛾蚋造成蝇蛆病的描述 图片来源:网络截图

这种虫子 看到1只 你家里就有了1万只——不是蟑螂
虽然没啥危害,但看着烦咋办?这样看来,偶尔从下水管道飞出来的白斑蛾蚋,并不是十恶不赦的大坏蛋。除了招人烦,它们也没啥实质性的大危害。如果实在看不惯它的存在,不妨试试这个简单的防治办法:定期向地漏倒入半杯食盐与苏打粉混合物,配合沸水冲洗。这种操作能够破坏白斑蛾蚋幼虫赖以生存的酸碱平衡环境,达到简单有效的短期灭杀效果。
向下水道中倾倒热水或药剂,的确可以杀灭蛾蠓虫卵,但下水道有很多回弯,而且蛾蠓的繁殖能力很强,所以这种办法是治标不治本的。可能处理过后的一段时间,它们又会出现在你的家中。想要根治蛾蠓,更好的办法可能是使用阻隔性能更强的地漏——既然没有办法将它们赶尽杀绝,就干脆断掉它们进入室内的通道。网友们各有妙招(说它吸血起大包的,其实是错怪了)图片来源:厦门疾控公众号

这种虫子 看到1只 你家里就有了1万只——不是蟑螂
值得深思的是,这种被人类视为下水道害虫的生物,其实也扮演着城市生态预警灯的角色。作为栖息在城市下水道的分解者,白斑蛾蚋孜孜不倦地帮人类消化着各类有机残余物。当其种群数量异常增大时,往往意味着排水系统存在着堆积堵塞的隐患。下次你在家里看到它的成虫,说明你家下水道该通一通啦!家里再看到它,你还会滋哇乱叫吗?图片来源:Wikimedia

这种虫子 看到1只 你家里就有了1万只——不是蟑螂
参考文献
[1] Jiménez-Guri E, Wotton KR, Gavilán B, Jaeger J. A Staging Scheme for the Development of the Moth Midge Clogmia albipunctata. PLoS ONE, 2014, 9(1): e84422.
[2]Vieira-Alc?ntara K, Chagas TPG, da Costa GL, Pinto TN, Oliveira MME, Zahner V. First Identification of Emerging Pathogenic Yeast in Clogmia albipunctata (Diptera: Psychodidae) at a Brazilian Hospital. Microorganisms, 2024, 12(12):2520.
[3]Rupprecht T , Moter A , Wiessener A ,et al. Spread of Multidrug-Resistant Bacteria by Moth Flies from Hospital Waste Water System. Emerging Infectious Diseases, 2020, 26(8):1893-1898.
[4]Speirs N B , Mahadik G A , Thoroddsen S T .How drain flies manage to almost never get washed away. Scientific Reports, 2020, 10(1).
[5]Mathison B A , Madriz I , Pritt B S ,et al. Psychodid flies and their implicated role in human myiasis and pseudomyiasis. Journal of Clinical Microbiology, 2024, 62(3).
[6]Akhoundi M , Ranorohasimanana N M , Brun S ,et al. Clogmia albipunctata (Nematocera; Psychodidae) as the Etiologic Agent of Myiasis: True or False?. Diagnostics (2075-4418), 2022, 12(9).
[7]何志伟,董起钰,刘锐,et al.白斑蛾蚋幼虫肠道可培养细菌的分离鉴定与产消化酶活性分析. 中国媒介生物学及控制杂志, 2021年32卷2期, 224-229页.
[8]https://en.wikipedia.org/wiki/Clogmia_albipunctata